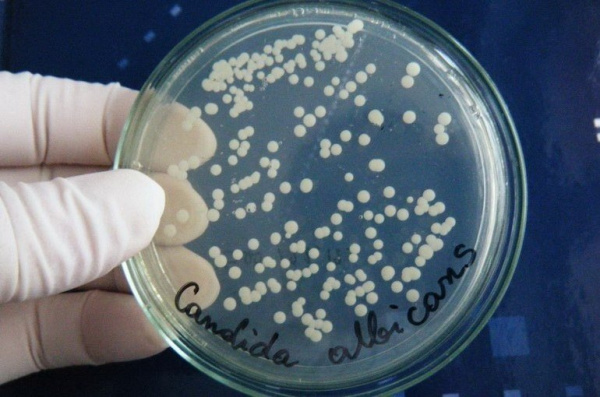
Посевной материал Candida albicans Посевной материал Candida albicans

Заражение молочницей у мужчин происходит во время полового акта
Заражение молочницей у мужчин происходит при половом акте с партнершей, во влагалище которой молочница проявляет патогенную активность.
При этом попадание грибка в мочевыводящие пути мужчины вовсе не будет означать, что он заболеет.
Эти микроорганизмы в большинстве случаев полностью и легко вымываются из мужского мочеиспускательного канала вместе с мочой.
Но если иммунитет мужчины ослаблен:
- инфекционные заболевания
- длительный прием антибиотиков
- злоупотребление алкоголем
- гипотермия
- хронический стресс

грибок может прижиться и вызвать развитие местной инфекции в области половых органов.
Кандидоз у мужчин чаще всего протекает скрыто, без каких-либо признаков.
Однако возможны и случаи выраженного клинического проявления инфекции.
Почему возникает молочница у мужчин?
А «у мужчин вообще есть комфорт» — часто спрашивают пациенты.
Да, молочница у мужчин встречается гораздо реже, чем у женщин.
В мужском организме кандида плохо приживается.
причиной этого является выделение грибка через уретральный канал вместе с мочой.
Для того чтобы комфорт начал развиваться в организме мужчины, необходимо воздействие определенных факторов.
Основными причинами комфорта у мужчин являются:
- Снижение эффективности иммунной системы
- Избыточный вес
- Наличие хронических заболеваний
- Длительное применение антибиотиков
- Стресс
- Депрессия
Кроме того, не исключайте пренебрежение интимной гигиеной.
Как видите, причины развития молочницы довольно разные.
Зная причины развития молочницы, следует подробно изучить ее симптоматические проявления.
Симптомы мужской молочницы
Обычно представлены признаками воспаления головки полового члена:
- Покраснение, отек слизистой оболочки
- Сухость, раздражение, повышенная чувствительность, болезненность головы
- Скопление белого налета под крайней плотью, напоминающего по виду творог
- Зуд, жжение при мочеиспускании
- Дискомфорт, дискомфорт во время или после секса
Анализы на молочницу Кандидоз (та же молочница) может возникнуть в любом возрасте у представителей обоих полов. Молочница наиболее опасна для новорожденных и беременных женщин.
Молочница: симптомы
При проявлении молочницы у мужчин следует обратиться к специалисту для проведения курса лечения.
Каковы симптомы молочницы у мужчин?
Различают следующие признаки молочницы:
- Боль во время полового акта и во время мочеиспускания
- Горящий пенис
- Гиперемия и отек головки полового члена
- Зуд
- Налет белого оттенка, внешне похожий на творог
- Выделения имеют специфический кисловатый запах
Такие выделения являются характерным симптоматическим проявлением молочницы как у мужчин, так и у женщин.
Наличие признаков позволяет врачу поставить предварительный диагноз.
Окончательный диагноз можно поставить только на основании результатов лабораторных исследований.
Анализы на молочницу у мужчин
Исследование на выявление молочницы начинается с визуального осмотра врачом.
Специалист осматривает половые органы и подтверждает наличие симптомов молочницы.
После детального изучения симптомов пациента врач назначает необходимый комплекс диагностических исследований.
Диагностика включает следующие тесты:
- Микроскопическое исследование мазка
- Бактериологический посев на молочницу
- ПЦР-анализ
- МФА
Бактериологическое исследование проводят путем посева патологического материала на специальную питательную среду (Сабуро).
Именно это питательное вещество предназначено для определения грибковой флоры.
Методы лабораторной диагностики являются важной частью постановки правильного диагноза.
Наиболее быстрой и точной является ПЦР-диагностика.
Может проводить ПЦР-тестирование на 3, 5 или 8 видов молочницы у мужчин
Мазок на флору при молочнице у мужчин
Материал для анализа берут из уретры стерильным зондом.
Вводится с внутренней стороны на пару сантиметров.
При наличии белого налета на головке полового члена ее также следует отправить на исследование.
Мазки на молочницу у мужчин помещают на предметное стекло и отправляют в лабораторию на анализ.
После обработки получают результаты анализа.
Укажите следующие свойства:
- Наличие эпителиальных клеток
- Есть ли лейкоциты и в каком количестве
- Наличие бактерий
- Есть ли в мазке грибок рода Candida
- Посмотрите, присутствует ли флора моллюсков
В случае обнаружения грибка назначают курс противогрибковой терапии.
Виды и стадии развития кандидоза у мужчин
Мужской кандидоз классифицируют по локализации, особенностям течения и другим параметрам.
По локализации:
- баланит – воспаление головки полового члена;
- баланопостит – воспаление головки полового члена и внутренней части крайней плоти;
- уретрит – воспаление уретры;
- дерматит – это воспаление кожи.
По характеру течения:
- острый – воспаление успешно лечится;
- хронический – симптомы сохраняются или вновь появляются вскоре после лечения.
По наличию осложнений:
- неосложненный – наиболее частый вариант течения, продолжается локально и полностью исчезает после лечения;
- осложненный – может возникать у больных с сильно ослабленным иммунитетом: инфекция попадает в кровь и может вызвать опасные состояния.
В Международной классификации болезней МКБ-10 кандидоз у мужчин имеет коды N51.2 (кандидозный баланит) и N37.0 (кандидозный уретрит).
Что позволяет грибкам размножаться
Candida albicans – грибок, для разрастания которого необходимо снижение местного и/или общего иммунитета, а также нарушение состава микробиоты в организме в целом. К основным факторам риска распространения генитального кандидоза у мужчин относятся:
- Предшествующее нерациональное лечение антибиотиками, особенно при использовании препаратов широкого спектра действия.
- Прием иммунодепрессантов (химиотерапия, системные, редко топические глюкокортикоиды).
- Врожденный или приобретенный иммунодефицит (например, ВИЧ-инфекция, сахарный диабет).
- Сахарный диабет и другие нарушения углеводного обмена, сопровождающиеся гипергликемией. Высокий уровень глюкозы в крови создает благоприятные условия для роста дрожжеподобных грибов.
- Нарушение интимной гигиены – карман между крайней плотью и головкой – хорошее место для роста и размножения кандиды.
- Использование местно-раздражающих средств гигиены – пены для ванн, туалетного мыла, мыла для душа, лубрикантов.
- Возникновение грибковой инфекции более вероятно на поврежденной и раздраженной слизистой оболочке (на фоне аллергических реакций, дерматитов).
- Нерациональное питание, белковая недостаточность и избыток быстроусвояемых углеводов в рационе.
- Наличие следующих хронических заболеваний: почечная/печеночная недостаточность, ожирение, метаболический синдром, подагра, гипотиреоз.
Диагностика
К какому врачу обратиться: урологу, венерологу, андрологу.
Врач берет мазок с пораженной поверхности, секрет простаты, эякулирует и исследует полученный биоматериал с помощью световой микроскопии. Диагноз подтверждается обнаружением разных форм гриба и его нитей. Бакпосев на питательной среде позволяет выяснить характер кандидоза, чувствительность к антибиотикам.

Дрожжеподобные грибы под микроскопом
Кто в группе риска

Врачи определяют факторы риска, которые могут увеличить вероятность развития инфекции. На основе этих знаний можно создать эффективную программу профилактики. Предрасполагающими факторами будут:
- Лекарства
Применение антибиотиков широкого спектра действия часто нарушает баланс микрофлоры, что позволяет грибкам практически бесконтрольно размножаться. Опасными в плане развития кандидоза будут и препараты, способные подавлять и нарушать работу иммунной системы: кортикостероиды, препараты, применяемые для химиотерапии.
- Дисфункция иммунной системы
Нередко комфорт появляется на фоне какой-то болезни, инфекции в холодное время года, проще говоря, в то время, когда иммунная система ослаблена. В группу риска попадают пациенты с серьезными заболеваниями внутренних органов и метаболических процессов.
- Избыточный вес и ожирение
Исследования показали, что пациенты с ожирением находятся в группе риска. Особенности тела и гигиенический уход создают более благоприятные условия для развития грибков.
- Плохая личная гигиена
Отсутствие удовлетворительной гигиены является одной из наиболее частых причин молочницы. Причем речь идет о ротовой полости и половых органах. В некоторых случаях средства гигиены могут спровоцировать кандидоз.
Исследования показали, что чаще всего от генитального кандидоза страдают мужчины, которые не подвергались обрезанию, то есть обрезанию.
Осложнения
При хроническом кандидозном баланопостите по краю препуциального мешка появляются трещины, что приводит к рубцеванию и сужению крайней плоти — формированию приобретенного фимоза. Невозможность обнажить головку полового члена и провести интимную гигиену усугубляет имеющееся воспаление, делает невозможным вести полноценную половую жизнь, а при неблагоприятных условиях может вызвать парафимоз.
Кандидозное воспаление является предрасполагающим фактором к заражению инфекциями, передающимися половым путем (ИППП), и другими видами бактериальных возбудителей. В тяжелых случаях в половом члене возникают гангрена и рожистое воспаление. Длительный воспалительный процесс вызывает бородавчатые разрастания и образование гранулем. При иммунодефиците не исключено гематогенное распространение грибов с развитием системного кандидоза.
Клинические проявления кандидоза у мужчин
Чаще всего кандидоз у мужчин проявляется в виде ограниченных форм – баланита и баланопостита. Но в ряде случаев при наличии других факторов, способствующих развитию кандидоза, могут наблюдаться более серьезные проявления – кандидозный уретрит и цистит.

1. Кандидозный баланит – поверхностная форма кандидоза полового члена. Это наиболее частое проявление генитального кандидоза у мужчин. Чаще всего имеет половое происхождение. При баланите поражается только головка полового члена. В зависимости от степени поражения кожи и слизистых оболочек может протекать в трех клинических формах: с образованием эрозий, пленок, ярко-красных пятен и везикул. Кроме того, на коже полового члена могут появляться очаговые шелушащиеся очаги гиперемии и экземоподобные высыпания. В процесс может вовлекаться кожа бедер, паховых складок и перианальной области. При развитии кандидозного баланопостита поражается не только головка полового члена, но и крайняя плоть. При этом на головке полового члена в области венечной борозды и на внутреннем листке крайней плоти отмечаются гиперемия, незначительная отечность и кожная инфильтрация. Участки мацерации покрыты бело-серым налетом, после снятия которого обнаруживается эрозионная поверхность красного цвета. На головке полового члена мелкие поверхностные эрозии, а на внутреннем листке крайней плоти беловатый пленочный налет. Крайняя плоть становится инфильтрированной, плохо и болезненно растяжимой, иногда с трещинами по краю. Воспалительные изменения сопровождаются зудом и жжением. При стертом течении кандидозного баланита отмечается лишь незначительная гиперемия венечной борозды и скопление белых мучнистых масс под внутренним листком крайней плоти, либо мелкие папулы и микроэрозии. Иногда кандидозный баланопостит может перейти в хроническую форму. При хроническом баланопостите вследствие появления трещин по краю крайней плоти и последующего рубцевания может происходить сужение крайней плоти с формированием стойкого фимоза.
2. Кандидозное воспаление уретры — кандидозный уретрит, встречается редко. Встречается не более чем у 3,5% всех больных, страдающих воспалительными заболеваниями уретры инфекционного характера. По клиническим проявлениям он подобен любому уретриту, возникающему при заражении инфекциями, передающимися половым путем, но чаще протекает менее остро. Больного беспокоят выделения из уретры разной степени выраженности, жжение и зуд при мочеиспускании. Следует отметить, что обычно картина уретрита сопровождается явлениями кандидозного баланита или баланопостита.
3. При воспалении мочевого пузыря (цистите) у больного появляется чувство тяжести в этой области, боли, часто отмечается учащение мочеиспускания. Моча мутная и может содержать кровь. Следует отметить, что клиническая картина кандидозного цистита напоминает цистит любой инфекционной природы и не имеет своих особенностей. Однако его можно заподозрить, если у больного имеются другие кандидозные поражения половых органов.
Симптомы баланопостита
Проявления баланопостита в целом не отличаются от воспалительных симптомов других локализаций. Чаще всего для заболевания характерна триада признаков воспаления: отек, боль и покраснение. Но вместо боли баланопостит обычно вызывает зуд и жжение в области поражения. На месте воспалительных очагов очень часто образуются эрозии (поверхностные раны), покрытые выделениями и бляшками белого или желто-зеленого цвета.
Одним из важных диагностических признаков заболевания является нарастание симптомов во время и после полового акта. Вследствие механического раздражения воспаленной кожи возникает покраснение, налет или зуд. Также симптомы баланопостита могут усиливаться во время и после мочеиспускания.
Серьезным симптомом выраженной воспалительной реакции является затрудненное и болезненное обнажение головы. Это связано не только с самим воспалением, но и с осложнениями в виде воспалительных спаек и фимоза (сужения крайней плоти). Спайки чаще всего возникают у детей. Они формируются через несколько дней после начала заболевания и развиваются в случае позднего обращения к врачу.
К каким докторам следует обращаться если у Вас Кандидоз мочеполовых органов (молочница) у мужчин:
Вы должны очень внимательно следить за своим здоровьем в целом. Люди не уделяют должного внимания симптомам болезней и не осознают, что эти болезни могут быть опасны для жизни. Есть много болезней, которые изначально никак не проявляются в нашем организме, но в итоге оказывается, что лечить их, к сожалению, уже поздно. Каждое заболевание имеет свои специфические признаки, характерные внешние проявления — так называемые симптомы болезни. Выявление симптомов является первым шагом в диагностике заболеваний в целом. Для этого просто необходимо несколько раз в год обследоваться у врача, чтобы не только предотвратить страшную болезнь, но и сохранить здоровый дух в теле и организме в целом.
Симптомы острой и хронической формы
Признаки баланопостита появляются вблизи головки полового члена и крайней плоти и могут варьироваться от легких до тяжелых.
Проявления баланопостита могут затруднить мочеиспускание и совершение полового акта.
Общие симптомы включают в себя:
- боль, нежность и раздражение;
- утолщение и утолщение крайней плоти, усиление рисунка кожи (лихенификация);
- обесцвеченная или «блестящая» кожа;
- зуд или жжение;
- очень сухая кожа на крайней плоти и головке полового члена;
- необычные выделения;
- неприятный запах от полового члена и выделений;
- сужение крайней плоти (фимоз);
- эрозии или повреждения кожи.
Симптомы хронической формы
При хроническом течении баланопостита симптомы будут выглядеть так:
- умеренный отек головки полового члена;
- постоянно обновляющийся налет на голове;
- неприятные переживания;
- покраснение и раздражение головки полового члена, крайней плоти через равные промежутки времени.
На поздних стадиях хронического баланопостита или при развитии острого процесса возможны такие явления, как:
- отек и болезненность полового члена;
- покраснение;
- мутная моча с примесью гнойных выделений;
- выделение гноя из-под крайней плоти, в некоторых случаях – крови;
- повышение температуры тела.
В крайне запущенных случаях баланопостита заболевание может перейти в некротическую форму – гангрену, которая проявляется:
- образование язв на крайней плоти и головке полового члена;
- почернение крайней плоти и головки (образование собственно некротических тканей);
- усиление боли и гипертермии до 39С и выше;
- признаки отравления продуктами некроза распада: мышечная слабость, жажда, снижение АД, нарушение сознания.
Сочетание симптомов обычно зависит от причины баланопостита. Например, процесс, вызванный грибковой инфекцией, может включать такие симптомы, как зуд, жжение и белое пятно вокруг головки полового члена и крайней плоти.
Можно ли заразиться молочницей от женщины
Хотя генитальный кандидоз у мужчин, особенно кандидозный баланопостит, чаще всего передается половым путем, его не относят к заболеваниям, передающимся при незащищенных половых контактах.
Это связано с тем, что грибы рода Candida могут присутствовать на слизистых оболочках мужчин и находятся в норме, а рост культуры связан со многими факторами (состоянием микрофлоры и иммунитета, гигиеной, наличием венерических заболеваний).
Секс не обязательно приводит к передаче кандидоза от инфицированной женщины к мужчине.
Но риск заражения все же есть, поэтому мужчинам из группы высокого риска следует избегать незащищенного секса с больной женщиной, пока она не выздоровеет.
В паре, где один из партнеров страдает от комфорта, мудро выбрать терапию как для мужчины, так и для женщины. Эта мера позволяет уменьшить циркуляцию грибков в паре
Патогенез
В механизме развития кандидозного баланопостита большое значение имеют факторы патогенности возбудителя: адгезия, диморфизм, биопленкообразование. Устойчивое прикрепление грибов к клеткам на поверхности полового члена обеспечивается за счет неспецифических гидрофобных контактов и специфических лиганд-рецепторных взаимодействий. Кроме того, имеет место инвазия, основанная на эндоцитозе с помощью инвазивных белков и прямом проникновении внутрь клетки.
Важнейшую роль в инвазии и дальнейшем распространении возбудителей играет способность к диморфизму — превращению из дрожжеподобной формы в настоящие гифы в зависимости от температуры, содержания кислорода и уровня рН среды. Грибы также способны образовывать биопленки, обладающие повышенной устойчивостью к противогрибковым препаратам и факторам иммунной системы больного, что вызывает трудности в лечении кандидозного баланопостита.
Посевной материал Candida albicans
Какой врач лечит
При возникновении раздражения вокруг головки полового члена или крайней плоти следует обратиться к врачу, специализирующемуся в области урологии (уролог) или кожных заболеваний (дерматолог-венеролог).
Маловероятно, что патология пройдет без специального лечения, хотя в редких случаях это возможно. Скорее всего, без лечения легкая катаральная стадия либо перейдет в хроническую форму, либо в гнойную, а затем в опасную гангрену.
Сочетание кандидозного баланопостита с другими патологиями
Сопутствующие заболевания могут привести к тяжелому или рецидивирующему кандидозу.
С одной стороны, они улучшают условия для грибов.
Они способствуют их чрезмерному размножению, что вызывает трудности в излечении больного.
С другой стороны, сама кандида способствует развитию других заболеваний.
Они нарушают нормальный биоценоз половой системы.
Часто кандидоз сочетается с такими патологиями:
- венерические заболевания
- неспецифический бактериальный баланопостит
- аллергические или кожные заболевания с локализацией патологических очагов на головке полового члена или крайней плоти
- повторяющиеся микротравмы
- все заболевания, сопровождающиеся лихорадкой и потливостью (тиреотоксикоз, длительная лихорадка — например, при туберкулезе, гипергидрозе, вегетативной дисфункции нервной системы по симпатотоническому типу)
Все сопутствующие заболевания должны быть выявлены и вылечены или компенсированы.
В противном случае рецидивы кандидозной инфекции будут продолжаться, так как будут создаваться благоприятные условия для развития грибка в организме.
Что провоцирует / Причины Кандидоза мочеполовых органов (молочницы) у мужчин:
возбудителем болезни являются в первую очередь виды Calbicans, реже — C tropicalis и C krusei. C albicans (albicans — беловатый, блестящий (лат.) — наиболее распространенный вид с наиболее выраженными патогенными свойствами среди всех возбудителей кандидоза.
Грибы рода Candida широко распространены в природе, они питаются предметами обихода, продуктами питания, в первую очередь богатыми сахаром овощами и фруктами. Они быстро и легко колонизируют кожу человека и слизистые оболочки, граничащие с внешней средой, в том числе слизистые оболочки ротоглотки, носа, пищеварительного и мочеполового трактов. По мнению многих авторов, грибы рода Candida связаны с нормальной микрофлорой организма человека, в связи с чем их довольно часто выделяют в культурах со здоровой слизистой уретры, влагалища и в посевах мочи.
При определенных условиях сапрофитные грибы рода Candida способны приобретать патогенные свойства. В таких случаях простые или мелкие элементы гриба, лежащие на здоровой слизистой оболочке, начинают интенсивно размножаться, образуя несколько нитчатых форм (псевдомицелий). Показателем паразитарной активности возбуждения является быстрое образование нитчатой формы гриба. Клетки грибов с новыми, патогенными свойствами прикрепляются к клеткам эпителия слизистой оболочки, прежде всего к клеткам, богатым гликогеном. Затем они выделяются в них и паразитируют в цитоплазме и ядрах, постепенно разрушая клетку-хозяина и образуя поражения слизистой оболочки.
Грибы продуцируют эндотоксин и ряд протеолитических, липолитических и сахаролитических ферментов. Действием этих ферментов объясняется ряд клинических симптомов, особенно интенсивный зуд при вагинальном кандидозе, обусловленный распадом углеводов в клетках эпителия слизистой оболочки влагалища на уксусную, муравьиную и пировиноградную кислоты, которые раздражают расположенные здесь многочисленные нервные окончания.
Основные причины кандидоза (молочницы) у мужчин
Хотя возбудители кандидоза могут передаваться половым путем, в большинстве случаев кандидоз не связан с половым контактом. Кандидоз не относится к венерическим заболеваниям и рассматривается вместе с ними в связи со схожей клинической картиной.
Факторы, способствующие развитию кандидоза:
— Врожденные и приобретенные иммунодефицитные состояния (ВИЧ-инфекция).
— Прием антибиотиков широкого спектра действия.
— Ослабление общего иммунитета (из-за резкой смены климата, сильного эмоционального стресса).
— Эндокринопатия (преимущественно сахарный диабет).
— Общие инфекции и отравления.
— Нарушение гомеостаза и нормального микробного баланса слизистых оболочек человека (дисбактериоз) под влиянием эндогенных (стрессы, местные инфекции) и экзогенных (кортикостероидные гормоны, антибиотики, цитостатики).
— Ослабление местной резистентности тканей и нарушение защитных механизмов слизистой оболочки: местное повреждение (механическое, термическое, химическое), мацерация, снижение слизеобразования железистого эпителия при наличии хронического или сопутствующего острого воспаления в половых органах.
Эпидемиология кандидоза мочеполовых органов у мужчин.
У мужчин развитию кандидоза нередко способствует экзогенная инфекция, а изолированные штаммы грибка нередко обладают повышенной патогенностью.
Кандидоз полового члена, возникший у мужчины после полового контакта с женщиной, страдающей кандидозным вагинитом, имеет другое название – «брачная молочница».
Поскольку кожа и слизистые оболочки половых органов здоровых людей сильно контаминированы грибами рода Candida, эндогенное инфицирование, а также занесение возбудителей с других участков кожи и слизистых оболочек, в первую очередь из прямой кишки, невозможно исключено. Следовательно, передача инфекции при анальном сексе от мужчины и передача инфекции через задний проход являются причиной первичного инфицирования влагалища или повторного заражения после лечения.
Контрольные анализы после лечения кандидозного баланопостита
После того, как человек прошел курс терапии, необходимо подтверждение выздоровления.
Осуществляется на основании:
- осмотр больного – врач должен осмотреть головку полового члена и крайнюю плоть, убедиться в отсутствии воспалительного процесса
- лабораторные исследования – берется мазок, изучается под микроскопом
Для большинства пациентов достаточно микроскопического исследования в качестве лабораторного метода для подтверждения заживления.
Если грибы не найдены, это означает одно из двух:
- они не здесь
- они есть, но в таких малых количествах, что уже не представляют угрозы для здоровья
В некоторых ситуациях лучше подтвердить излечение с помощью ПЦР с количественным определением ДНК грибов.
Это необходимо, если:
- заболевание, вызванное атипичным кандидозом
- человек длительное время лечился от хронического или рецидивирующего кандидозного баланопостита
- заболевание развилось серьезно, что привело к осложнениям
Тогда целью лечения является не снижение количества отдельных видов кандиды, а полное их уничтожение в области гениталий.
ПЦР-тест более чувствителен, поэтому в данном случае именно он подтвердит положительные результаты терапии.
Общие сведения
Поражение половых органов грибами Candida является типичной локализацией поверхностного кандидоза у мужчин, на долю которого приходится более 87% всех нозологических форм. Кандидозное воспаление составляет 35% инфекционного баланопостита. Выделяют 2 диагностических пика: возраст 18-30 лет, который связан с активной половой жизнью, и возраст старше 50 лет, когда возникают различные нарушения здоровья, способствующие активизации возбудителей. Кандидозный баланопостит чрезвычайно актуален в практической урологии в связи с его распространенностью, частыми рецидивами и возможными опасными осложнениями.

Кандидозный баланопостит
Когда при кандидозном баланопостите нужны ПЦР и посев
В большинстве случаев используется диагностика путем оценки симптомов и микроскопии биоматериала.
Этого достаточно, чтобы установить диагноз и назначить лечение.
ПЦР и посев необходимы только в определенных ситуациях:
- при тяжелом кандидозе
- при его хронической форме
- если пациент не реагирует на лечение
- при частых рецидивах грибковой инфекции
Микроскопический метод не дает возможности определить вид грибка, вызвавшего воспаление.
В 80% случаев это Candida albicans.
Однако этот гриб редко вызывает хронические процессы.
Обычно легко уничтожается фунгицидами и редко возвращается.
Если есть проблемы, это, скорее всего, свидетельствует о наличии атипичной кандиды.
Для точного определения вида грибка проводят ПЦР.
Это метод молекулярно-генетической диагностики, направленный на поиск определенного фрагмента ДНК.
Он характерен только для определенного вида грибов.
Таким образом, по результатам ПЦР врач может установить причину инфекции.
Это облегчает ему выбор терапевтической схемы.
Потому что разные виды грибков чувствительны к разным лекарствам.
Флуконазол не убивает большинство атипичных кандид.
Они имеют пониженную устойчивость к нему или полностью устойчивы к нему.
Посев – еще более информативный метод.
Суть его заключается в том, что гриб высевают на питательную среду.
Емкость со средой культивируют в течение нескольких дней в оптимальных для кандиды условиях (температура, влажность, питательные субстраты).
Затем оценивают рост колоний.
По их разным характеристикам можно определить точный вид гриба.
Кроме того, специалисты могут проверить на живой культуре, какие вещества убивают этот вид кандиды.
В результате врач получает список противогрибковых средств, к которым грибок имеет высокую, низкую устойчивость или полностью устойчив.
Для лечения врач назначает препарат, чувствительность к которому сохраняется на высоком уровне.
С большой долей вероятности такая схема терапии приводит к успеху.
Особенности возбудителя
Для проявления патогенных свойств грибов рода Candida необходимы определенные условия. В таких условиях сапрофитные формы грибов, находящиеся на здоровой коже или слизистых оболочках, начинают интенсивно размножаться, образуя несколько нитчатых форм. Показателем паразитарной активности возбуждения является быстрое образование нитчатой формы гриба. Клетки грибов с новыми болезнетворными свойствами прикрепляются к эпителиальным клеткам слизистой оболочки. При проникновении в клетку они начинают в ней паразитировать, что приводит к воспалению. Грибы продуцируют эндотоксин и ряд протеолитических ферментов. Действием этих ферментов объясняется ряд клинических симптомов, особенно интенсивный зуд при кандидозе гениталий. Хотя возбудители кандидоза могут передаваться половым путем, в большинстве случаев кандидоз не связан с половым контактом. Кандидоз не относится к венерическим заболеваниям, но может напоминать их из-за схожести клинических симптомов.
Несколько фактов о мужской молочнице
- Кандиду можно обнаружить на всех участках тела, но чаще всего в теплых и влажных местах (полость рта, влагалище, подмышки, крайняя плоть, межпальцевые области и так далее).
- Кандидоз у мужчин редко возникает сам по себе, необходимы предрасполагающие факторы.
- Генитальный кандидоз обычно не считается инфекцией, передающейся половым путем (ЗППП), хотя грибковая передача может происходить при половом контакте.
- Прогрессирование инфекции у мужчин без патологии общего иммунитета и других предрасполагающих факторов можно предотвратить, соблюдая правила интимной гигиены.
- Наличие венерических заболеваний у мужчины (хламидиоз, уреаплазмоз, гонорея и так далее) повышает вероятность генитального кандидоза.
- https://kvd-moskva.ru/molochnitsa/381/
- https://gemotest.ru/info/spravochnik/zabolevaniya/kandidoz-u-muzhchin/
- https://sterilno.net/infection/fungal-infections/simptomy-lechenie-kandidoza-u-muzhchin.html
- https://VashUrolog.com/zppp/molochnica.html
- https://MedAboutMe.ru/articles/kandidoz_u_muzhchin_simptomy_sovremennoe_lechenie/
- https://www.KrasotaiMedicina.ru/diseases/zabolevanija_andrology/candidal-balanoposthitis
- https://viferon.su/kandidoz-u-muzhchin/
- https://ProBolezny.ru/balanopostit/
- https://www.eurolab-portal.ru/diseases/318/
- https://www.diagnos.ru/diseases/masculina/balanopostit
- [https://sifilis24.ru/simptomy/%D0%BA%D0%B0%D0%BD%D0%B4%D0%B8%D0%B4%D0%BE%D0%B7%D0%BD%D1%8B%D0%B9-%D0%B1%D0%B0%D0%BB%D0%B0%D0%BD%D0%BE%D0%BF%D0%BE%D1%81%D1%82%D0%B8%D1%82-%D1%83-%D0%BC%D1%83%D0%B6%D1%87%D0%B8%D0%BD.html]
